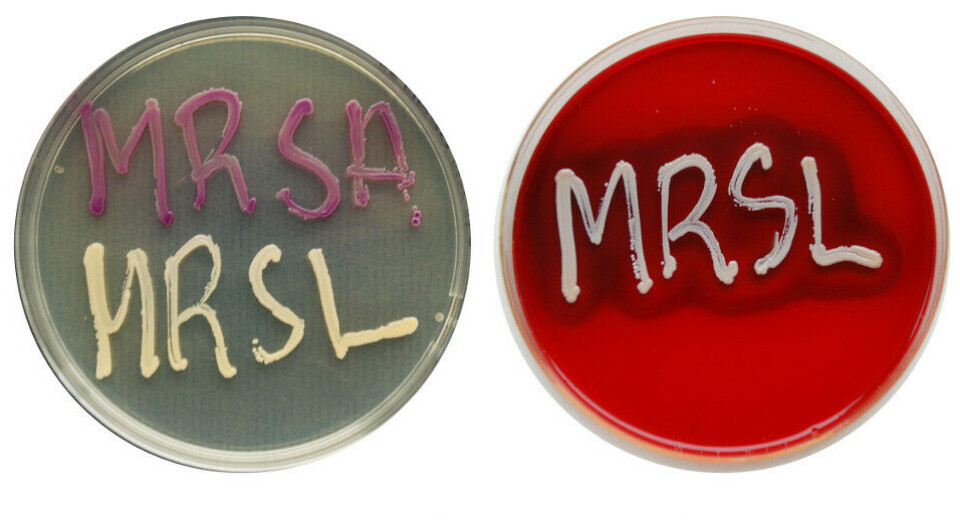
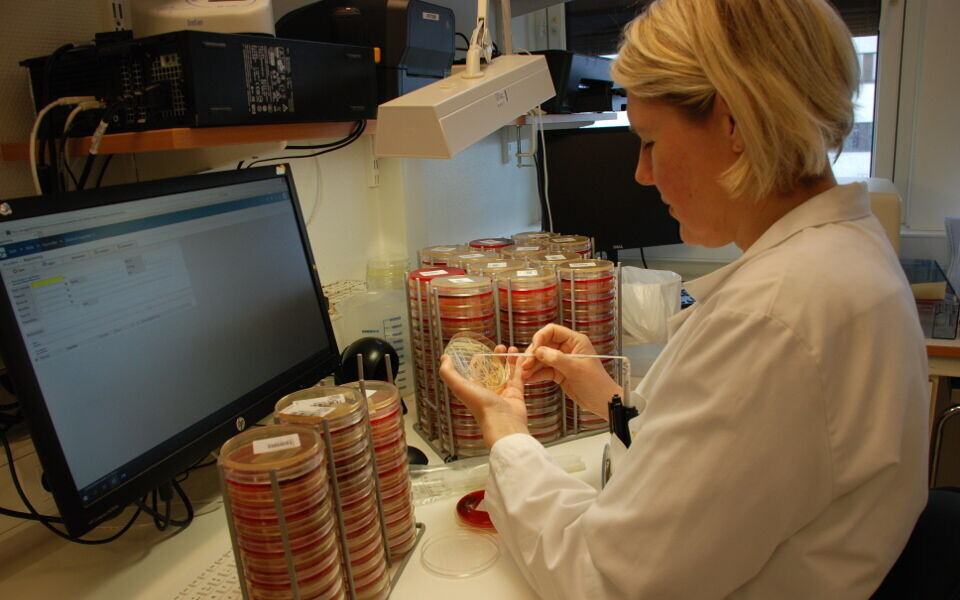
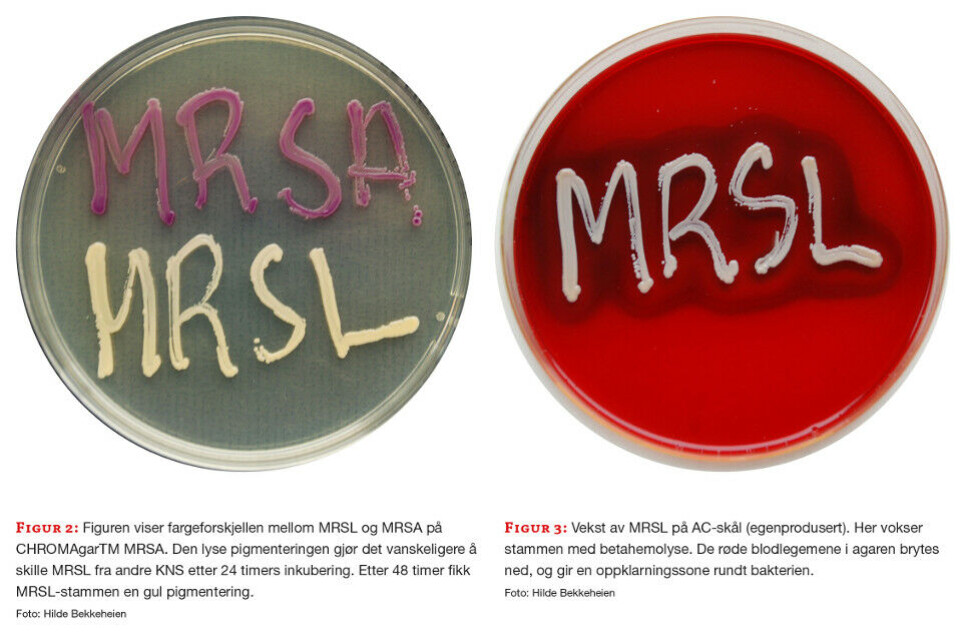

Fag i praksis
Utbrudd av Staphylococcus lugdunensis med uvanlig resistensmønster
Funn avStaphylococcus lugdunensismed meticillinresistens hos en pasient innlagt ved nyfødt intensiv medførte screening av pasienter, ansatte og pårørende for å hindre videre spredning. I denne artikkelen beskriver vi utbruddet og metodeutfordringer i forbindelse med resistenstestingen.
Av ANITA LØVÅS BREKKEN, HILDE BEKKEHEIEN og HEIDI SYRE
Utbrudd av Staphylococcus lugdunensis med uvanlig resistensmønster.pdf(320 KB)
På avdeling for medisinsk mikrobiologi, seksjon for bakteriediagnostikk ble det i desember 2020 påvist en S. lugdunensis med nedsatt følsomhet for meticillin hos et barn på nyfødt intensiv. Siden bakterien var resistent mot antibiotika som vanligvis brukes til behandling av stafylokokkinfeksjoner, ble det raskt satt i gang tiltak for å få oversikt over situasjonen og unngå smitte til andre nyfødte på avdelingen. I samarbeid med seksjon for smittevern ble det iverksatt screeningundersøkelser.
Meticillinresistente S. lugdunensis ble påvist i flere av prøvene og funnene ble definert som et utbrudd. Både screeningen og resistenstestingen av bakterien medførte utfordringer.
Staphylococcus lugdunensis
S. lugdunensis er Gram-positive kokker som tilhører Staphylococcus-slekten. Stafylokokker deles i koagulasenegative stafylokokker (KNS) og koagulasepositive stafylokokker. S. lugdunensis er en KNS og kan være en del av normalflora på hud, men kan også gi tilsvarende infeksjoner som S. aureus (koagulasepositiv stafylokokk). S. lugdunensis-infeksjoner bør derfor behandles på samme måte som infeksjoner med S. aureus. (1). Den vanligste infeksjonen forårsaket av S. lugdunensis er hud og bløtdelsinfeksjoner, men bakterien kan også forårsake infeksjon i bein (osteomyelitt), ledd (septisk artritt), hjerteklaffer (endokarditt), urinveisinfeksjoner, proteseinfeksjoner og blodforgiftning (sepsis). Korrekt identifikasjon er viktig. Det kan være vanskelig å skille S. lugdunensis fra andre KNS på morfologisk utseende med biokjemiske tester. Identifikasjon ved hjelp av MALDI-TOF (massespektrometri) har vært til god hjelp for laboratoriene.
Meticillinresistens
Meticillin er et smalspektret penicillin som hemmer dannelsen av celleveggen hos stafylokokker. Meticillin ble tidligere brukt i behandling av stafylokokkinfeksjoner, men er i dag stort sett erstattet av kloksacillin/dikloksacillin (2). Meticillinresistente stafylokokker brukes likevel som betegnelse for stafylokokker som er resistente mot betalaktamantibiotika.
Betalaktamantibiotika er den største og viktigste gruppen av antibiotika, og inkluderer blant annet penicilliner, cefalosporiner og karbapenemer. Meticillinresistente S. aureus (MRSA) er mest kjent, men også andre stafylokokker kan være meticillinresistente. Resistensen skyldes opptak av et nytt gen (mecA eller mecC) som koder for et annerledes penicillinbindende protein; PBP2a eller PBP2c. PBP er proteiner med enzymaktivitet som er viktig i celleveggsyntesen. Betalaktamantibiotika virker ved å binde seg til PBP og hemmer dermed bakteriens celleveggsyntese.
Resistensforhold hos S. lugdunensis
S. lugdunensis resistensbestemmes på laboratoriet dersom den antas som sannsynlig patogen i mottatt prøve. Vi benytter et standard resistenspanel for stafylokokker. I motsetning til andre KNS er S. lugdunensis vanligvis følsom for de fleste antibiotika som benyttes til behandling av infeksjoner forårsaket av stafylokokker (1). Meticillinresistens og påvisning av mecA er beskrevet hos S. lugdunensis, men ikke vanlig. I motsetning til MRSA, er ikke meticillinresistente S. lugdunensis (MRSL) meldepliktige, men referanselaboratoriet for MRSA, St. Olavs hospital i Trondheim, ønsker disse stammene tilsendt.
Prøve fra indekspasient
Prøven fra indekspasienten ankom laboratoriet vårt i desember 2020. Prøvematerialet var nasopharynxsekret på Eswab® (Copan, Italia) og ble dyrket på blod- og sjokoladeagarskål. De hyppigst forekommende patogene bakterier i luftveiene vokser på disse. Etter inkubering i CO2 over natten vokste både S. aureus og S. lugdunensis. Pasientopplysninger medførte at stammene ble resistensbestemt for både perorale og intravenøse antibiotika. S. aureus-stammen produserte penicillinase, en type betalaktamase som bryter ned og gjør bakterien resistent for smalsprektrede penicilliner, men var ellers følsom for de antibiotika den ble testet for. S. lugdunensis gav oss mer utfordringer.
Cefoxitin et et betalaktamantibiotika som brukes på laboratoriene til screening av meticillinresistens. Anbefalt brytningspunkt er 22 mm fra EUCAST/NordicAST (S≥22, R<22). Utfordringer i forbindelse med intern kvalitetskontroll for cefoxitin gjør at vårt laboratorium har innført egendefinert ATU (Area of technical uncertainty) (22-26 mm) for cefoxitin.
Alle metoder er beskrevet i egen metodeboks. Bakteriestammen (S. lugdunensis) fra indekspasienten ble målt til 25 mm for cefoxitin ved lappediffusjon (OXOID, UK). Verdien var i vårt ATU-område og medførte ekstra testing. Til neste dag ble det testet med cefoxitin MIC strips (MTS, Liofilchem, Italia) ved agargradientdiffusjon og minste hemmende konsentrasjon (MIC) ble målt til 32 mg/L. I NordicAST sin brytningspunkttabell 2021 oppgis MIC>4 mg/L som grense for resistens, og stammen ble oppfattet som resistent. Resultat fra lappediffusjon og gradientdiffusjon plasserte utbruddsstammen i ulike følsomhetskategorier for cefoxitin og vi kunne ikke konkludere angående meticillinresistens. Stammen ble derfor testet med PCR-metodikk for påvisning av mec-gen. Vanligvis benyttes en in-house metode til mec-påvisning. På grunn av omprioriteringer under den pågående covid-19-pandemien, ble GeneXpert® (Cepheid, USA) brukt til dette. GeneXpert® kan påvise både mecA og mecC, men differensierer ikke mellom genene. I tillegg påvises SCCmec (Staphylococcal cassette chromosome) som markør for S. aureus. Utbruddsstammen var som forventet negativ for SCCmec, men mec-gen ble påvist (figur 1). Tilstedeværelsen av mec-gen forklarer den nedsatte følsomheten for cefoxitin.

Screeningresultater
Helsetjenestene må ha system for smittevern (3). Ved påvisning av samme bakteriestamme hos to eller flere personer med antatt felles kilde, mistenkes et smitteutbrudd. Utbrudd må oppdages og begrenses så raskt som mulig, noe som er spesielt viktig når utbruddsstammen er resistent mot viktige antibiotika. Funn av MRSL ble varslet både internt i avdelingen, til nyfødt intensiv og til seksjon for smittevern ved sykehuset. Det ble besluttet å utføre screeningundersøkelse for påvisning av MRSL.
Det ble tatt screeningprøver på Eswab® fra nese, hals og perineum på alle pasienter ved nyfødt intensiv, fra nese og hals på alle ansatte og fra pårørende til pasienter med påvist MRSL. Ved screening for MRSA dyrkes prøvene på CHROMAgarTM MRSA(CHROMAgar). Skålen har høy sensitivitet og spesifisitet for MRSA (4), men er ikke validert for andre meticillinresistente stafylokokker. Leverandør angir at MRSA skal vokse med rosa eller blek lilla kolonier, mens andre mikrober er hemmet, fargeløse eller blå.
Vi ønsket å bruke denne skålen i screeningen for MRSL. Bakteriestammen fra indekspasienten vokste med lys gule kolonier (figur 2). Vi inkluderte i tillegg en skål der vi visste at S. lugdunensis vokste (figur 3). Dette er en egenprodusert skål med blodagar tilsatt aztreonam og colistin (AC-skål). MRSA-skålen har fra leverandør anbefalt dyrkningstid 18-24 timer for MRSA. Bakteriestammen vokste litt langsommere enn S. aureus, og vi valgte å inkubere screeningprøvene i 48 timer før de eventuelt ble besvart som negative.
Mange KNS er meticillinresistente og S. lugdunensis på MRSA-skålen var ikke lett å skille fra andre KNS etter 24 timer. Ved inkubering i inntil 48 timer fikk MRSL en tydelig gulere pigmentering enn andre KNS. Identifikasjon ble utført med MALDI-TOF (Bruker Daltonics, Tyskland) på kolonityper som lignet på S. lugdunensis. AC-skålen ble brukt som støtte og vekstkontroll for å lettere finne S. lugdunensis etter 24 timer og fordi MRSA-skålen ikke er validert for MRSL. Funn av S. lugdunensis på MRSA-skålen og AC-skålen ble undersøkt for mecA/C med GeneXpert®. Alle funn av MRSL i screeningprøvene vokste på MRSA-skålen. Ingen av stammene med mec-gen vokste kun på AC-skålen.
Stammene med påvist mec ble resistensbestemt med standard resistenspanel for MRSA ved avdelingen. I tillegg til meticillinresistens, var utbruddsstammen resistent mot gentamicin og doksycyklin. Ved resistensbestemmelse med lappediffusjon varierte cefoxitinsonene fra 20-26 mm, ved agargradientdiffusjon varierte cefoxitin MIC fra 16– 32 mg/L (figur 4 og 5).

Stammene ble sendt til nasjonalt referanselaboratorium for MRSA for nærmere analyse, funn av meticillinresistens ble bekreftet, og mec-A ble påvist. Helgenomsekvensering viste at stammene var svært nær beslektet. Til sammen har laboratoriet i løpet av utbruddet mottatt nesten 500 screeningprøver og MRSL ble påvist hos til sammen ti personer.
Diskusjon
Cefoxitin er markør for meticillinresistens (5). Avdelingen har godt innarbeidede prosedyrer for påvisning av MRSA, både i kliniske prøver som blir resistensbestemt og i prøver som skal screenes for MRSA. MRSL er ikke vanlig, men utbruddet har vist oss at det er viktig å ha prosedyrer for også å fange opp KNS med meticillinresistens.
Laboratoriene utfører kvalitetskontroller for å sikre god kvalitet, også ved resistensbestemmelse. Antibiotika som brukes i forbindelse med resistensbestemmelse blir testet jevnlig ved bruk av referansestammer anbefalt av EUCAST (6). Laboratoriene får også tilsendt sammenlignende laboratorieprøver (SLP) fra eksterne leverandører. Disse analyseres som kliniske prøver, fasit og eventuelle kommentarer fra leverandør brukes i kvalitetsarbeidet ved laboratoriet.
Resultat fra kvalitetskontroller for cefoxitin ved vårt laboratorium viser større sonediameter ved resistensbestemmelse av stafylokokker enn det vi ønsker, både for sensitive og resistente stammer. Antibiotikalapper og Mueller Hinton-agar er fra OXOID, UK. Cefoxitin screeningsbrytningspunkt for S. aureus og andre KNS (unntatt S. epidermidis) er 22 mm i gjeldende brytningspunkttabell versjon 11.0. For S. epidermidis er tilsvarende brytningspunkt 25 mm (S≥25 og R<25 mm) og i tillegg er det definert et ATU-område på 25-27 mm. Vi har i tillegg innført egendefinert ATU på 22-26 mm for S. lugdunensis, S. aureus og S. argenteus for ikke å overse noen meticillinresistente stafylokokker. Screening med cefoxitin for å påvise meticillinresistens hos S. aureus er en metode med høy grad av sensitivitet og spesifisitet (5). For å fange opp all meticillinresistens hos KNS er metoden mindre pålitelig (figur 6).

Høsten 2020 sendte Folkehelseinstituttet (FHI) ut en «ringtest» (SLP) som inneholdt S. lugdunensis med nedsatt følsomhet for cefoxitin og mec-A (Prøve 277/3-2020). Stammens mm-sone for cefoxitin var rett rundt brytningspunktet og utfordret laboratorienes evne til å påvise meticillinresistens hos KNS. Av de 23 laboratoriene som mottok prøven var det 17 som påviste nedsatt følsomhet for cefoxitin. Vårt resultat for cefoxitin på ringteststammen var 22 mm, den ble derfor undersøkt for mec-gener med positivt resultat for mecA.
Med utgangspunkt i denne SLP-prøven er det i ettertid blitt en diskusjon på MikInfo (FHI) angående kategorisering og brytningspunkt for cefoxitin for KNS. Representanter fra MRSA referanselaboratorium informerte om at de har mottatt 30 mecA positive S. lugdunensis de siste årene og at 11 av disse hadde en mm-sone på ≥22 mm. Med et brytningspunkt på 22 mm vil 37% av S. lugdunensis med mecA bli feilrapportert som cefoxitinfølsomme. De presiserer at laboratoriene bør ha lav terskel for genotypisk testing av stafylokokker påvist hos pasienter med alvorlige eller kompliserte stafylokokkinfeksjoner, selv om stammene er sensitive ut fra fenotypisk resistensbestemmelse.
På bakgrunn av dette mener vi at brytningspunktet fra EUCAST bør endres slik at man ved fenotypiske resistensbestemmelse klarer å påvise meticillinresistens hos alle stafylokokker, og dermed også S. lugdunensis. AFA har i samarbeid med MRSA referanselaboratorium sendt inn et forslag til EUCAST om endring av cefoxitins screeningbrytningspunkt (personlig meddelelse, P.C.Lindemann, AFA/EUCAST).
På laboratoriet ved SUS kommer vi til å fortsette med vår egendefinerte ATU for cefoxitin og stafylokokker. Vi vil også utføre genotypisk testing på klinisk viktige cefoxitinfølsomme KNS der resistensbestemmelse skal rapporteres ut til rekvirent. Påvisning av meticillinresistens er viktig for korrekt antibiotikabehandling av pasienten. For håndtering av MRSA finnes det nasjonale retningslinjer i smittevernveilederen (7) og personer med MRSA skal saneres. Det finnes ingen slike nasjonale retningslinjer for MRSL. Bakterien kan forårsake infeksjoner tilsvarende S. aureus og resistensmekanismen er den samme som hos MRSA. Det er derfor naturlig at personer med påvist MRSL forsøkes sanert, særlig dersom de har kontakt med helsetjenester.
MRSL-utbruddet ble ressurskrevende for laboratoriet. Bakteriestammen fra indekspasienten ble oppdaget i det desember. Som vanlig, var det planlagt lavere bemanning jule- og nyttårshelgen. Av smittevernhensyn måtte screeningen starte raskest mulig for å få en oversikt over situasjonen, og ekstra personell ble tilkalt både jule- og nyttårshelgen.
Konklusjon
Diskusjonen om å endre brytningspunkter for KNS og cefoxitin, eventuelt lage nye anbefalinger, pågår. Vi håper det kommer endringer som gjør at laboratoriene ikke feilkategoriserer antibiotikafølsomheten hos stafylokokker. Klinikerne har behov for våre svar, og pasienten har krav på best mulig behandling.
Det er ikke tidligere rapportert om utbrudd av MRSL i Norge. Ansatte ved de mikrobiologiske laboratoriene spiller en viktig rolle i forbindelse med påvisning av resistente bakterier. God kompetanse innenfor resistensbestemmelse hos både bioingeniører og leger er nødvendig. Prosedyrer må være oppdaterte og i henhold til anbefalinger fra EUCAST/NordicAST. Laboratoriet må ha kvalitetsprogrammer og håndtere eventuelle avvik på en god måte og ha datasystem som håndterer kommentarer og advarsler.
Infeksjoner med multiresistente bakterier er forbundet med økt sykelighet og dødelighet, forlenget liggetid i sykehus og høyere kostnader. Når det skjer uventede funn av resistente bakterier, er det viktig med godt samarbeid internt i avdelingen. Det er også avgjørende med god kommunikasjon og godt samarbeid med klinikerne og smittevernansatte i forbindelse med utbruddshåndtering. Utbruddshåndteringen har vært krevende, men også veldig lærerik.
Takk til
IT-koordinator ved avdelingen vår, MRSA referanselaboratorium og EUCAST-utviklingslaboratorium.